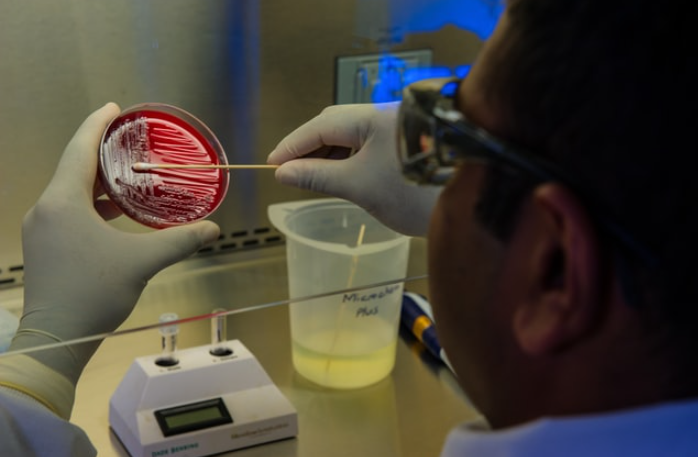
Ekran Görüntüsü 2025 08 06 111555
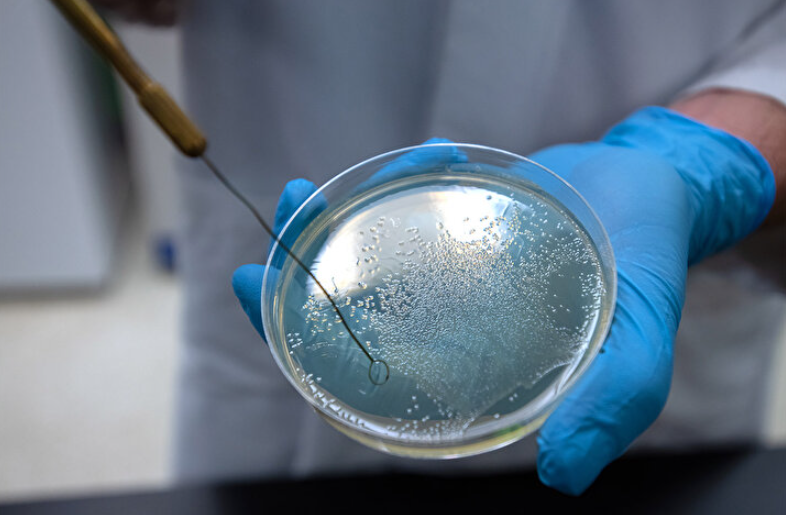
Ekran Görüntüsü 2025 08 06 111539
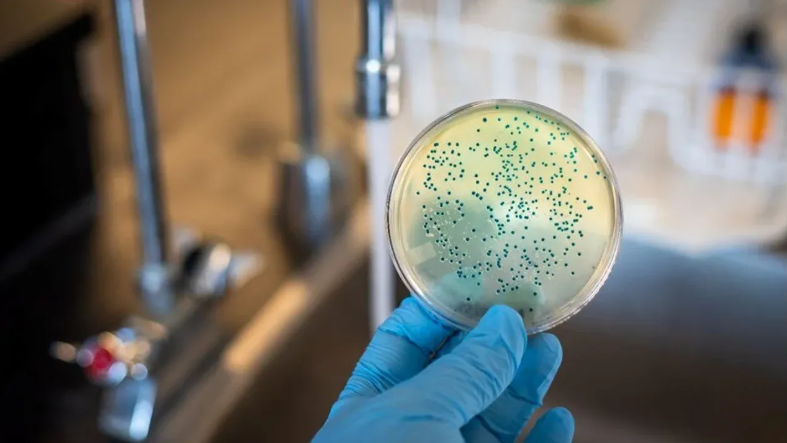
Ekran Görüntüsü 2025 08 06 111528

ECDC’nin raporuna göre, Vibrio bakterileri sıcak ve düşük tuzluluk oranına sahip sularda hızla çoğalıyor. İstanbul Florence Nightingale Hastanesi Üroloji Uzmanı Op. Dr. Uğur Aferin, özellikle Vibrio vulnificus’un açık yaralardan vücuda girerek ciddi doku enfeksiyonlarına yol açabileceğini belirtiyor. “Halk arasında ‘et yiyen bakteri’ olarak bilinen bu tür, nadir de olsa nekrotizan fasiit gibi ölümcül sonuçlara neden olabilir” diyen Aferin, bağışıklık sistemi zayıf bireylerin daha yüksek risk altında olduğunu ekliyor.
Vibrio parahaemolyticus ise genellikle çiğ veya az pişmiş deniz ürünleri, özellikle istiridye tüketimiyle bulaşıyor. Bu bakteri, karın ağrısı, ishal, kusma ve ateş gibi belirtilerle kendini gösteriyor. Bağışıklığı düşük kişilerde enfeksiyonun kana karışarak sepsise yol açma riski bulunuyor. Uzmanlar, Alanya gibi yoğun turist çeken bölgelerde çiğ deniz ürünü tüketiminde dikkatli olunması gerektiğini vurguluyor.
ALANYA’DA RİSK ALTINDAKİ GRUPLAR VE KORUNMA YOLLARI
ECDC, Alanya gibi sıcak iklimi ve kalabalık plajları olan şehirlerin bakteri yayılımı için uygun bir zemin oluşturduğuna dikkat çekiyor. Özellikle açık yarası olanlar, bağışıklık sistemi zayıf bireyler, çiğ deniz ürünü tüketenler ve uzun süre ıslak mayo ile kalanlar yüksek risk taşıyor. Dr. Aferin, ıslak mayonun genital bölgede nemli bir ortam yaratarak bakteriyel enfeksiyonları tetikleyebileceğini, bu durumun özellikle kadınlarda idrar yolu enfeksiyonlarına yol açabileceğini belirtiyor.
Uzmanların önerdiği korunma yöntemleri ise şöyle:
- Açık yaraların su geçirmez bandajlarla kapatılması,
- Denizden çıktıktan sonra temiz suyla duş alınması,
- Çiğ veya az pişmiş deniz ürünlerinden kaçınılması,
- Islak mayo ile uzun süre kalınmaması,
- Ciltte kızarıklık, şişlik, ateş veya ishal gibi belirtiler görüldüğünde derhal sağlık kuruluşuna başvurulması.
TURİZM BÖLGELERİNDE EK ÖNLEMLER GEREKLİ
Alanya’nın mavi bayraklı plajları ve yoğun turist trafiği, bölgedeki hijyen koşullarının önemini artırıyor. ECDC, yerel yönetimlerin ve turizm işletmelerinin deniz suyu kalitesini düzenli olarak test etmesi ve halkı bilgilendirmesi gerektiğini vurguluyor. Ayrıca, havuzların da rotavirüs, hepatit A ve E. coli gibi patojenler açısından risk taşıyabileceği belirtiliyor. Çocuk Sağlığı ve Hastalıkları Uzmanı Dr. Hüseyin Yıldız, özellikle dört aylıktan küçük bebeklerin denize, altı aylıktan küçüklerin ise havuza girmemesi gerektiğini ifade ediyor.



